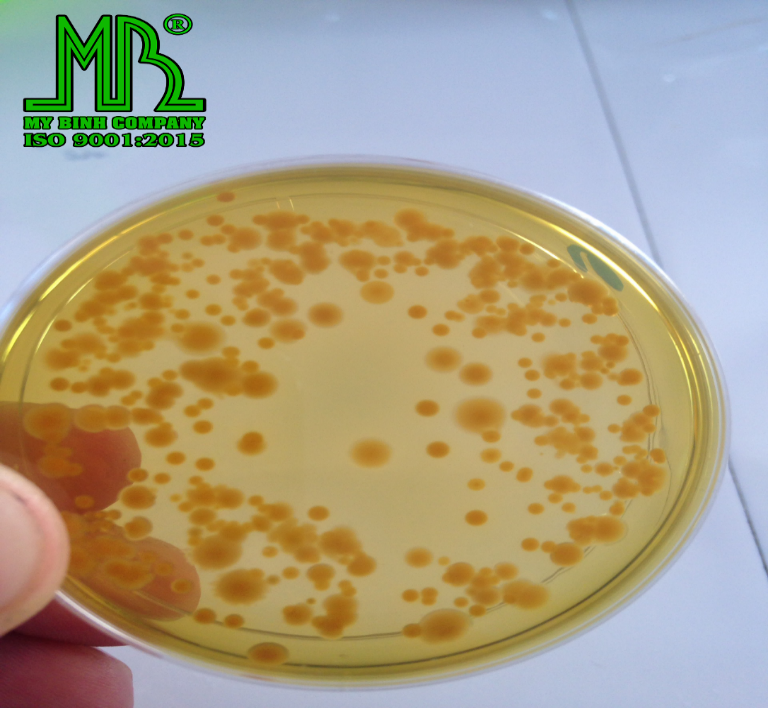

PITO ZYME – Men tiêu hóa "quốc dân"
Đường ruột là bộ phận quan trọng nhất của tôm và chúng có cấu tạo cơ thể rất đơn giản nên rất dễ mẫn cảm với các loại bệnh. Bệnh đường ruột ở tôm khá phổ biến, ảnh hưởng rất lớn đến sự thành công của vụ nuôi, nếu không có biện pháp phòng và điều trị có thể làm giảm năng suất, chất lượng, ảnh hưởng đến hiệu quả nuôi trồng của bà con.
Công ty TNHH Thương Mại XNK Mỹ Bình xin mời quý bà con tham khảo bài chia sẻ dưới đây để hiểu rõ thêm về bệnh ở đường ruột và cách phòng- trị bệnh hiệu quả.
Biểu hiện của bệnh:
Khi bị mắc bệnh đường ruột ở tôm thường có những biểu hiện như bỏ ăn, bơi lờ đờ, tấp bờ, đường ruột bị loãng và đứt quãng, phân trắng, phân lỏng, đứt đoạn. Tôm rất sợ tiếng động và ánh sáng. Nếu bị nhẹ thì tôm sẽ có mủ cuối đuôi và có đốm trắng, xuất huyết đường ruột. Nếu tôm bị nhiễm bệnh mà bà con tiếp tục cho ăn nhiều thì tôm sẽ càng chết nhanh và ngày một nhiều. Khi tôm bị nhiễm bệnh chỉ cần sau 2 đến 3 ngày thì sẽ chết.
Vậy nguyên nhân từ đâu?
Dinh dưỡng: Do tôm ăn thức ăn bị nhiễm nấm mốc hoặc ăn phải tảo độc trong ao. Khi đó ruột tôm bị tác động bởi độc tố nấm mốc từ thức ăn hoặc các enzyme do tảo độc tiết ra (ví dụ như tảo lam) sẽ gây độc cho tôm, sự tiêu hóa dưỡng chất bị đình trệ, tôm thể hiện phân trắng, đường ruột đứt khúc.
Do tảo độc: Trong ao nuôi thường tồn tại nhiều loại tảo khác nhau, trong đó có nhiều loại tảo có khả năng tiết ra enzyme làm tê liệt lớp biểu mô ruột, làm ruột tôm không thể hấp thụ được thức ăn. Điển hình như tảo lam, khi trong ao có nhiều tảo lam sẽ có tình trạng tôm bị phân trắng, phân đứt khúc do tôm ăn tảo lam và không thể tiêu hóa được.
Do ký sinh trùng đường ruột: Các loại ký sinh trùng bám trên thành ruột làm tôm bị bệnh đường ruột.
Kí sinh trùng Gregarines
Kí sinh trùng Vermiform
Do vi khuẩn: Vi khuẩn (Vibrio proteolyticus và Vibrio alginolyticus) cũng là nguyên nhân chính gây ra bệnh phân trắng trên tôm. Khi môi trường ô nhiễm các loài vi khuẩn, virus phát triển mạnh và xâm nhập vào cơ thể tôm gây bệnh.
Khuẩn ở đường ruột cao
Giải pháp hữu hiệu và an toàn:
Với tinh thần luôn mong muốn được làm người bạn đồng hành suốt vụ mùa cùng bà con, Công ty TNHH Thương Mại XNK Mỹ Bình đã nỗ lực và không ngừng cải tiến công nghệ để mang đến những sản phẩm chất lượng, vì thế PITO ZYME được nghiên cứu và cải tiến nhằm hỗ trợ phòng và điều trị các bệnh về đường ruột với thành phần chính là: Vi khuẩn Bacillus subtilis và Lactobacillus acidophilus. Những công dụng nổi bật mà PITO ZYME mang đến:
Giúp tiêu hóa nhanh thức ăn
Ức chế các vi khuẩn gây bệnh đường ruột từ đó giảm nguy cơ nhiễm các bệnh đường ruột như ruột lỏng, đứt khúc, phân trắng trên tôm,..
Cải thiện hệ thống tiêu hóa sau khi sử dụng kháng sinh.
Cách phòng và điều trị hiệu quả với sản phẩm PITO ZYME :
Liều dùng hằng ngày cho phòng bệnh trên tôm là 5g/1 kg thức ăn
Khi tôm có hiện tượng ruột lỏng, đứt khúc hoặc sau quá trình trị bệnh phân trắng ta thực hiện cho ăn với liều 10g – 15g/1 kg thức ăn (3-4 cử/ngày).
Bên cạnh đó, để giảm tối thiếu bệnh về đường ruột bà con nên lưu ý:
Lựa chọn những loại thức ăn chất lượng cao, có nguồn gốc rõ ràng. Bảo quản thức ăn nơi khô ráo, tránh để bị ẩm mốc.
Theo dõi hàng ngày sức ăn của tôm để điều chỉnh lượng thức ăn cho phù hợp, tránh dư thừa.
Định kỳ sử dụng men vi sinh để phân hủy các bã hữu cơ có trong ao, làm sạch nước ao, hạn chế sự phát triển của các sinh vật gây hại. Bà con có thể tham khảo sản phẩm vi sinh “O3” để giải quyết được hết những vấn đề này.
Trộn men tiêu hóa “PITO ZYME” vào khẩu phần ăn của tôm để tăng sức đề kháng, kích thích đường ruột, giúp tôm tiêu hóa tốt, tăng trưởng nhanh.
Mọi thắc mắc về kỹ thuật hay thông tin sản phẩm trong bài, bà con vui lòng liên hệ qua Hotline 0911 383 533 để được các kỹ thuật viên của công ty trực tiếp giải đáp.
Chúc quý bà con có vụ mùa bội thu!